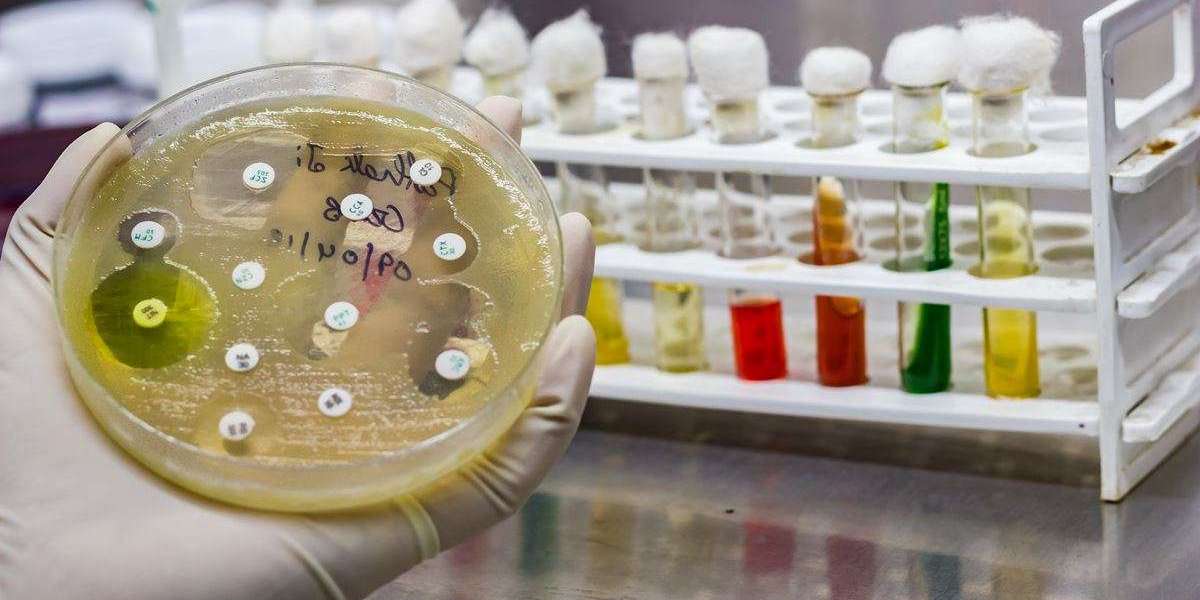

The Asia Pacific Data Center Colocation Market size is projected to reach US$ 43.38 Bn at the end of the forecast period at a CAGR of 18.55%.
Asia Pacific Data Center Colocation Market Overview:
Maximize Market Research is a Business Consultancy Firm that has published a detailed analysis of the Asia Pacific Data Center Colocation Market. The report includes key business insights, demand analysis, pricing analysis, and competitive landscape. The report provides the current state of the Asia Pacific Data Center Colocation market by thorough analysis, and projections are made up to 2030.
Explore additional details by clicking the link provided:https://www.maximizemarketresearch.com/request-sample/7791/
Asia Pacific Data Center Colocation Market Scope and Methodology:
The Asia Pacific Data Center Colocation market report covers a wide range of topics that impact market dynamics, trends, opportunities, and challenges. It also includes a thorough analysis of the worldwide landscape. This comprehensive analysis also looks at how the market is divided into segments according to services category, company size, end-user sector, and geographical regions. The study also closely examines major industry participants, assessing their approaches, line of business, results, and place in the Asia Pacific Data Center Colocation market. To give a comprehensive picture of the market environment, a thorough evaluation of macroeconomic variables, regulatory frameworks, and technical developments is also carried out.
Also, the research offers detailed insights into the dynamics of the Asia Pacific Data Center Colocation market, including opportunities, challenges, constraints, and drivers. Using a bottom-up methodology, estimates of the size of the worldwide and regional Asia Pacific Data Center Colocation market were developed. The study provides a thorough value chain analysis that clarifies the Asia Pacific Data Center Colocation production process and incorporates information about distributors, consumers, and raw materials. Furthermore, the use of PORTER and PESTLE studies, in conjunction with evaluations of market attractiveness, enhances comprehension of the Asia Pacific Data Center Colocation market on a global and micro level.
Asia Pacific Data Center Colocation Market Segmentation:
By Type
• Retail Colocation
• Wholesale Colocation
The Asia Pacific data center colocation market has been bifurcated into retail colocation, and wholesale colocation. Large enterprises, and small & medium industries are the various end-users that are considered within the scope of the report.
By End-user
• Large Enterprises
• Small & Medium Industries
By Industry
• Banking, Financial Services, and Insurance (BFSI)
• Government and defence
• IT and telecom
• Healthcare
• Research and academics
• Energy
• Retail
• Manufacturing
• Others
The Asia Pacific data center colocation market is divided into banking, financial services, and insurance (BFSI), government and defence, IT and telecom, healthcare, research and academics, energy, retail, manufacturing, and others.
To access more comprehensive information, click here:https://www.maximizemarketresearch.com/request-sample/7791/
Asia Pacific Data Center Colocation Market Key Players:
• Equinix, Inc.
• AT&T, Inc.
• China Telecom Corporation Limited
• Interxion Holding NV
• Cyxtera Technologies, Inc,
• Verizon Enterprise Solutions, Inc.
• Salesforce
• Oracle Corporation
• Colt Technology Services
• China Unicom
• ChinaNetCenter
• 21Vianet
• Tencent
• KT Busan
• Anexia
• Hostway
• Telstra Global
• Kddi Corporation
• TATA Communications
• Reliance Communications
• Shanghai Atrium
• SUNeVision
• GDS Services
Request a sample copy of the report to see what's inside:https://www.maximizemarketresearch.com/request-sample/7791/
Asia Pacific Data Center Colocation Market Regional Insights :
The size and trends in the Asia Pacific Data Center Colocation market in each of the following regions are thoroughly examined in this research: North America (which includes the United States, Canada, and Mexico); Europe (which includes France, Spain, Germany, Italy, and other European countries); Asia-Pacific (which includes China, Japan, India, Australia, South Korea, ASEAN countries, and others APAC countries); South America (which includes Argentina, Brazil, and other South American countries); and Middle East and Africa (which includes South Africa, Egypt, and other MEA countries).
For an in-depth analysis, click the provided link:https://www.maximizemarketresearch.com/market-report/asia-pacific-cata-center-colocation-market/7791/
Key questions answered in the Asia Pacific Data Center Colocation Market are:
- What is Asia Pacific Data Center Colocation?
- What was the Asia Pacific Data Center Colocation market size in 2022?
- Which are the factors expected to drive the Asia Pacific Data Center Colocation market growth?
- Who are the leading companies and what are their portfolios in Asia Pacific Data Center Colocation Market?
- What growth strategies are the players considering to increase their presence in Asia Pacific Data Center Colocation?
- What are the upcoming industry applications and trends for the Asia Pacific Data Center Colocation Market?
- What will be the CAGR at which the Asia Pacific Data Center Colocation market will grow?
- What are the recent industry trends that can be implemented to generate additional revenue streams for the Asia Pacific Data Center Colocation Market?
- What are the different segments of the Asia Pacific Data Center Colocation Market?
- What is the growth rate of the Asia Pacific Data Center Colocation Market?
- What segments are covered in the Asia Pacific Data Center Colocation Market?
- Who are the key players in the Asia Pacific Data Center Colocation market?
- What are the key challenges and opportunities in the Asia Pacific Data Center Colocation market?
- Which application holds the highest potential in the Asia Pacific Data Center Colocation market?
Related Reports:
Conductive Carbon Black Companies https://www.maximizemarketresearch.com/competitive-analysis/conductive-carbon-black-companies/260419/
Digital Twin Companies https://www.maximizemarketresearch.com/competitive-analysis/digital-twin-companies/260421/
Key Offerings:
- Past Market Size and Competitive Landscape (2018 to 2022)
- Past Pricing and price curve by region (2018 to 2022)
- Market Size, Share, Size & Forecast by different segment | 2023−2029
- Market Dynamics – Growth Drivers, Restraints, Opportunities, and Key Trends by Region
- Market Segmentation – A detailed analysis by segment with their sub-segments and Region
- Competitive Landscape – Profiles of selected key players by region from a strategic perspective
- Competitive landscape – Market Leaders, Market Followers, Regional player
- Competitive benchmarking of key players by region
- PESTLE Analysis
- PORTER’s analysis
- Value chain and supply chain analysis
- Legal Aspects of Business by Region
- Lucrative business opportunities with SWOT analysis
- Recommendations
About Maximize Market Research:
Maximize Market Research is a multifaceted market research and consulting company with professionals from several industries. Some of the industries we cover include medical devices, pharmaceutical manufacturers, science and engineering, electronic components, industrial equipment, technology and communication, cars and automobiles, chemical products and substances, general merchandise, beverages, personal care, and automated systems. To mention a few, we provide market-verified industry estimations, technical trend analysis, crucial market research, strategic advice, competition analysis, production and demand analysis, and client impact studies.
Contact Maximize Market Research:
3rd Floor, Navale IT Park, Phase 2
Pune Banglore Highway, Narhe,
Pune, Maharashtra 411041, India
sales@maximizemarketresearch.com
+91 96071 95908, +91 9607365656